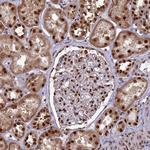
DDX1 Antibody in Immunohistochemistry (Paraffin) (IHC (P))

Search
Invitrogen
DDX1 Polyclonal Antibody
{{$productOrderCtrl.translations['antibody.pdp.commerceCard.promotion.promotions']}}
{{$productOrderCtrl.translations['antibody.pdp.commerceCard.promotion.viewpromo']}}
{{$productOrderCtrl.translations['antibody.pdp.commerceCard.promotion.promocode']}}: {{promo.promoCode}} {{promo.promoTitle}} {{promo.promoDescription}}. {{$productOrderCtrl.translations['antibody.pdp.commerceCard.promotion.learnmore']}}
产品信息
PA5-83226
种属反应
宿主/亚型
分类
类型
抗原
偶联物
形式
浓度
规格
纯化类型
保存液
内含物
保存条件
运输条件
RRID
产品详细信息
Immunogen sequence: NQALFPACVL KNAELKFNFG EEEFKFPPKD GFVALSKAPD GYIVKSQHSG NAQVTQTKFL PNAPKALIVE PSRELAEQTL NNIKQFKKY
Highest antigen sequence indentity to the following orthologs: Mouse - 96%, Rat - 94%.
靶标信息
DDX1 (ATP-dependent RNA helicase DDX1) acts as an ATP-dependent RNA helicase. It is able to unwind both RNA-RNA and RNA-DNA duplexes. DDX1 possesses 5' single-stranded RNA overhand nuclease activity and ATPase activity on various RNA, but not DNA polynucleotides. DDX1, together with RELA, acts as a coactivator to enhance NF-kappa-b-mediated transcriptional activation. It also acts as a positive transcriptional regulator of cyclin CCND2 expression. It binds to the cyclin CCND2 promoter region. DDX1 is a component of a multi-helicase-TICAM1 complex that acts as a cytoplasmic sensor of viral double stranded RNA and plays a role in activation of a cascade of antiviral responses including the induction of proinflammatory cytokines via the adapter molecule TICAM1.
仅用于科研。不用于诊断过程。未经明确授权不得转售。
篇参考文献 (0)
生物信息学
蛋白别名: Asp-Glu-Ala-Asp box; ATP-dependent RNA helicase DDX1; DBP-RB; DEAD (Asp-Glu-Ala-Asp) box helicase 1; DEAD (Asp-Glu-Ala-Asp) box polypeptide 1; DEAD box polypeptide 1; DEAD box protein 1; DEAD box protein retinoblastoma; DEAD box-1; DEAD-box RNA helicase DDX1; DEAD/H (Asp-Glu-Ala-Asp/His) box polypeptide 1; DEAD/H-box helicase 1; unnamed protein product
基因别名: AA409185; DBP-RB; DDX1; UKVH5d
UniProt ID: (Human) Q92499, (Rat) Q641Y8, (Mouse) Q91VR5
Entrez Gene ID: (Human) 1653, (Rat) 84474, (Mouse) 104721